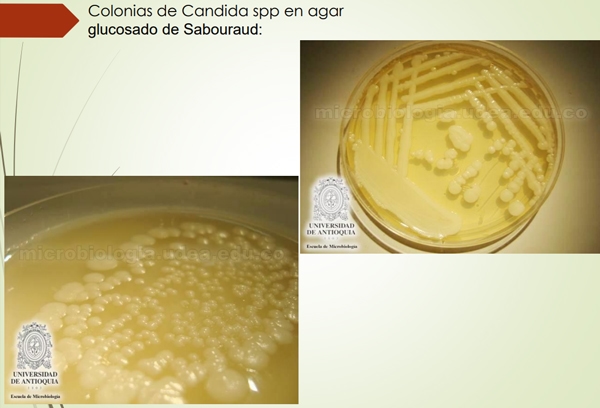

Género Candida.
Publicado: 4 de febrero de 2021
Fuente: Javier Israel Soliz Campos


Etimología
- La palabra candida es el femenino del adjetivo en latín candidus, “blanco brillante”.
- Llamado anteriormente Monilia, el nuevo término fue acuñado en 1923 (en lat. cient) por Christine Marie Berkhout.
Hábitat y ecología
- Saprófitos oportunistas de las mucosas humanas y animales, sobre todo de la mucosa oral, digestiva y genital. Además de hallar se en vegetales y suelos.
- Las micosis causadas por Candida se denominan (candidiasis) especialmente en pacientes con inmunosupresión.
Factores de virulencia
- Disformismo del hongo para desarrollar un crecimiento levaduriforme y filamentoso, el cual favorece la evasión de los mecanismos defensivos del hospedador.
- Adhesinas: que permiten la unión de la célula fúngica a los receptores del hospedador o a materiales plásticos utilizados en medicina, como las prótesis y los catéteres.
- Proteinasas y fosfolipasas: Las cuales corresponden a enzimas que favorecen la diseminación por los tejidos del hospedador
- Tigmotropismo: que permite encontrar discontinuidades entre las células y penetrar en los tejido
- Producción de toxinas y sustancias inmunosupresoras.
Características celulares.
- Célula oval o polimorfa, levaduriforme, de 2 a 5 micrómetros de largo.
- Presenta blastoconidias, hifas y pseudohifas, etc.
- Cápsulada.
- Se reproducen asexualmente por un proceso específico de división celular conocido como gemación.
- Todas las levaduras son Gram positivas, pero en algunas ocasiones la forma de las blastosporas puede variar de ovoide a elongada o esférica. Presentan clamidiosporas.
- Microscópicamente, C. albicans presenta dimorfismo, el cual es una transformación de la forma ovoide de las blastosporas (levaduras) germinales a hifas.


Características culturales y morfológicas de las colonias
Son exigentes, requieren medios nutritivos o con sangre. Pueden cultivarse en agar Sangre, pero es mejor el Agar glucosado de Sabouraud: medio diferencial de crecimiento; con un pH 5,6. A 25°C. Durante 24-48h.
Las colonias son lisas, brillantes, de color blanco o ligeramente beige. Con el tiempo se vuelven plegadas, rugosas o membranosas. El reverso de la placa Petri es blanco o crema. No se produce pigmento difusible. Presencia de filamentos sumergidos en el agar.


Características bioquímicas
- Utilización de medios de cultivo cromogénicos.
- Formación de seudomicelio, hifas y clamidoconidios en agar harina de maíz con Tween 80.
- Formación de clamidoconidios en agar Niger.
- Asimilación de carbohidratos y compuestos nitrogenados (auxanograma: manuales y automatizados).
- Fermentación de carbohidratos (zimograma).
- Formación de tubo germinativo (filamentación) en levaduras cultivadas en suero humano a 37°C.
- Serotipificación.

Revisión de enfermedades
Es una enfermedad de carácter zoonótico.
Clasificación:
Superficial: afectan mucosas orales y genitales
- Oral o muguet
- Faringe
- Genital(vaginitis, balanitis) ETS.
Profunda: Lesiones agudas que afectan uno o más órganos La mortalidad 50% complicación de una enfermedad




CERVERA, Cala H. CANDIDIASIS CRÓNICA. Robinbook. 2003. Barcelona
LAFORET, Leslie. estudio de pga 26, una proteína implicada en la arquitectura de la pared celular de candida albicans.
http://www.facmed.unam.mx/deptos/microbiologia/ micologia/candidosis.html [04/07/16]
Temas relacionados:
Autores:

Recomendar
Comentar
Compartir

¿Quieres comentar sobre otro tema? Crea una nueva publicación para dialogar con expertos de la comunidad.